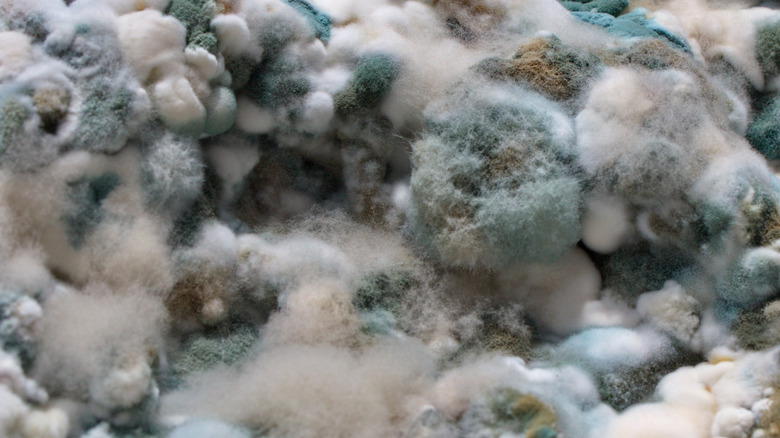
A close-up of mold on cottage cheese

The Food Safety Reason You Should Remove Seals Completely After Opening Containers
Under-lid seals are one of the many illusions of modern packaging. They're a shiny, reassuring layer that tells you your yogurt or peanut butter made it safely through trucks, warehouses, and grocery carts. But they're not a cloak of permanent protection. The seal's entire purpose is to protect the food before you open it. Once peeled, its job is finished, and keeping it around actually starts to do the opposite of its intention.
The trouble is touch. Most of us peel back seals with hands that may or may not be freshly washed, perhaps after handling groceries and doorknobs, or touching a phone screen. This transfers microbes, and with every touch, more arrive to the party. There's skin bacteria like staph, stray viral particles, and anything lurking on cutting boards and fridge handles, all invisible to the naked eye. The inside lip of a container is a particularly high-traffic zone because you interact with it until the container is empty — a peel-back seal is the commuter train that directly shuttles in microbes. If you've ever opened something resealed and noticed the peel looking rumpled, damp, or flecked with food residue, imagine what you can't see.
Some people may be operating under an erroneous (but persistent) belief that leaving a seal half-attached helps keep things fresher. In reality, the seal stops doing anything once you've broken it. Manufacturers design the lid and container to protect the food and verify the product traveled safely and wasn't tampered with. Leaving it draped over the opening just adds another potentially contaminated surface hovering above your food, nothing more.
Seal the deal... by removing it
Think of the seal as a "handle" you keep touching; except unlike the fridge door or faucet, it doesn't get disinfected during a deep clean. Studies on cross-contamination show how easily microbes transfer from hands to packaging and then to food-contact surfaces. Even a fingertip can deposit enough bacteria to speed spoilage, especially around a container's high-contact, inner rim. This is also why it's crucial to always use a clean spoon or knife when you're dipping into a container. If you don't, you're inevitably creating a petri dish. You might not see it at first, but you will eventually, or worse, you'll feel it.
Moisture makes everything worse. When a seal is left half-peeled, an air gap forms between the lid and the container rim. When a humid mixture of warm and cold air hit the surface of the foil (or plastic) seal, and condensation forms, a thin film of water clings to the underside. That becomes a micro-climate where mold spores can take hold. The seal also creates a visual barrier, obscuring signs of spoilage like small patches of mold, off-color streaks, or separated liquid.
There's a physical risk, too. Foil and peelable liners degrade quickly once bent and re-bent. Tiny shards can shear off and fall into the container. This is a cumulative mishandling that shortens shelf life, and is why the safest technique remains the simplest one: Wash your hands first, remove the seal completely when you open a product, and then throw it in the trash.